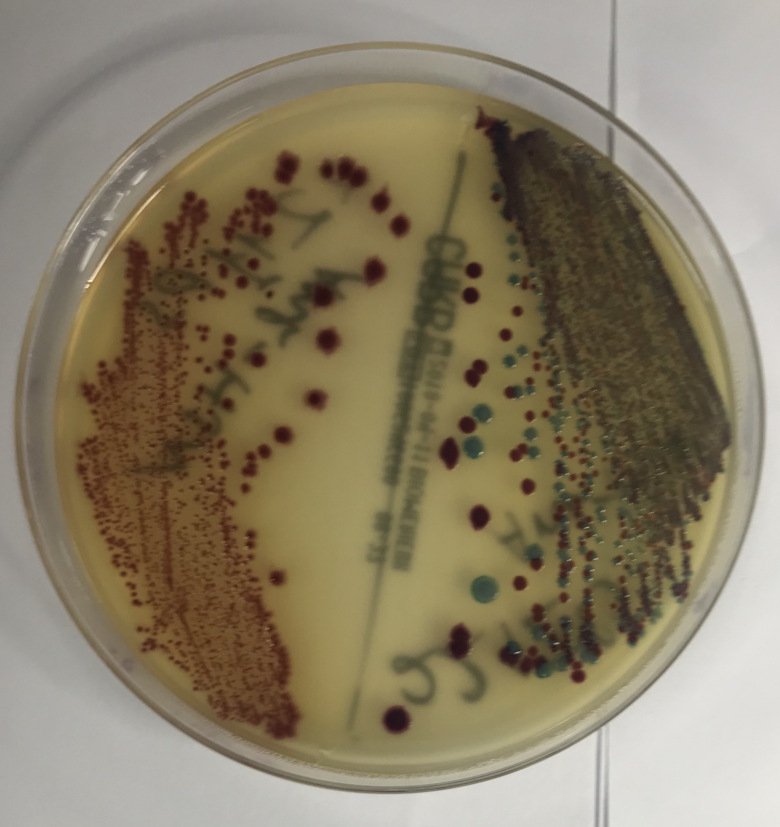
CRE (Carbapenem-resistant Enterobacteriaceae) bacteria-

About our research
Our vision is to enable the best possible health for all children, with a particular focus on children in poor and vulnerable environments. The group focuses on child health through an SDG lens and our research strives to be multidisciplinary and drive evidence-informed policy making. Key foci of our work are on identifying and addressing bottlenecks within the health system to make the most essential care available.
Research areas
Child health has seen a lot of progress in the last thirty years, under-five mortality has decreased by more than half, many more children go to school and fewer children live in extreme poverty. However, 5 million children still die before their fifth birthday and the differences in risk between different countries can be as great as 50-fold. And survival is not enough, we must give children and adolescents the possibility to thrive on a healthy planet.
Our research projects are divided across seven research themes to cover the various areas of global child health:
- Case management and emergency care
- Technology and innovation
- Infectious diseases and outbreak control
- Newborn care
- Child development
- Adolescent mental health and well-being
- Multi-sectoral and policy research, including climate change
Photo: Unknown KITuberculosis and the Sustainable Development Goals research team
Tuberculosis and the Sustainable Development Goals is a research team in the Global Child Health and Sustainable Development Goals research group. The team is focusing on tuberculosis (TB), with a main focus on social interventions to improve access and mitigate the disease-poverty trap, linking SDG 3 with SDGs 1, 2 and 8 among others. The team is also studying innovative pathways for TB screening and diagnosis.
Global collaborations
Photo: N/ACentre of Excellence for Sustainable Health
The Centre of Excellence for Sustainable Health is a collaboration between Makerere University in Uganda and Karolinska Institutet that aims is to develop capacity and mobilise actions to drive the agenda for sustainable health.
Photo: N/AHOLICARE
Bridging the gap between technological excellence, available infrastructure, capacity and local uptake of technologies to tackle the challenge of diagnostic, treatment and prevention of respiratory tract infections.
Events
The research group in the media
Photo: N/AProfessor Johan Lundin's research in NewScientist
News article about group member Professor Johan Lundin och collagues research on how AI can spot parasites in stool samples to help diagnose infections.
Photo: iStockPremature birth - one of the leading causes of death for children under five
Tobias Alfvén guests Swedish radio (Nyheter Ekot) to discuss the need to reduce death from premature birth, a leading cause of death for children under the age of five.
Photo: N/ABirger Forsberg guests podcast from Forum on Health Policy
With a background in social medicine, Birger Forsberg has seen the whole world in general and Region Stockholm in particular through the lens of public health. He has also had the privilege of leading the work on Region Stockholm's future planning, which makes for an interesting discussion when he guests Swedish podcast Hälso- och sjukvårdspodden, run by Forum for Health Polcy.
Photo: PrivateNewspaper Curie meets Giulia Gaudenzi
Assistant professor Giulia Gaudenzi is interviewed by the newspaper Curie about her work on the development and understanding of point-of-care diagnostics in Uganda (in Swedish).
Photo: Martin StenmarkWe need to address the systems perspective to achieve sustainable global health
Stefan Swartling Peterson, Professor of Global Systems Transformation for Health is interviewed by Kristina Ström Olsson, board member of the Forum for Health Policy. Stefan highlights several issues for achieving sustainable health (in Swedish).
Photo: N/ATobias Alfvén answers questions in Swedish TV from parents about children and virus season
We are in the middle of the virus season, which is noticeable among parents with young children. After the holidays, illnesses can now increase again. 'It's winter, and there are a lot of sick children,' says Tobias Alfvén, pediatrician at Sachsska Children's and Youth Hospital.